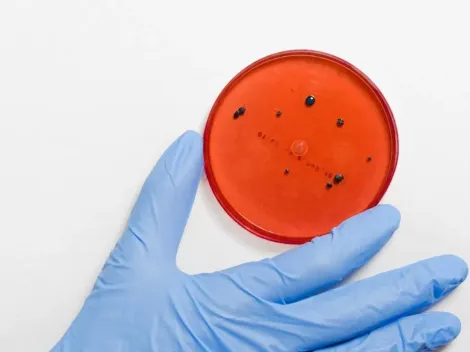
Viruela del mono: ¿Qué es y cómo se transmite?

La nueva ola de Coronavirus está azotando a todo el país y el Estado de Nuevo León es uno de los más afectados en este comienzo de año y el fútbol no es ajeno a esta problemática. De hecho, Rayados tuvo a cinco de sus jugadores con el virus en lo que va del 2022, a los que hay que sumar a Luis Romo, quien aún no se ha recuperado.
El refuerzo proveniente de Cruz Azul estuvo ausente en el empate sin goles de Monterrey contra Querétaro por la primera fecha del Torneo Clausura, partido tras el cual volvieron a hacerse los hisopados protocolares. Los resultados son preocupantes para el campeón de la Concachampions, ya que se confirmaron cuatro positivos nuevos, dos pertenecientes al cuerpo técnico.
De acuerdo con “TUDN”, los positivos restantes pertenecen al plantel y serían Rodolfo Pizarro y Jesús Gallardo, el único de los dos que sumó minutos frente a los Gallos Blancos. El lateral por izquierda estuvo poco más de media hora en el campo de juego, algo que también enciende las alarmas en Querétaro.
El club tiene planeado hacer un segundo testeo con pruebas PCR para reconfirmar los nuevos positivos este lunes. De no encontrarse con resultados contradictorios, ambos futbolistas estarían descartados para el cruce con Necaxa del próximo viernes, que se disputará en el Estadio Victoria – Aguascalientes desde las 9:00 p.m.